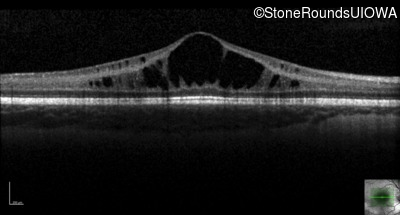
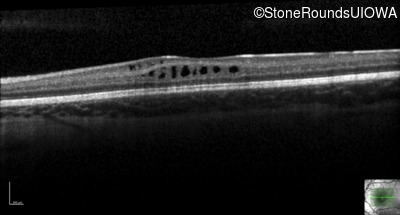
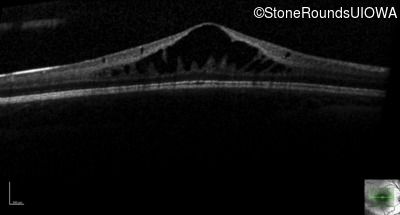
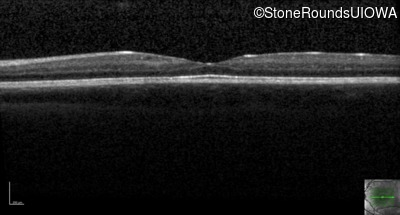
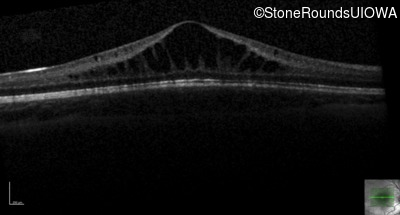
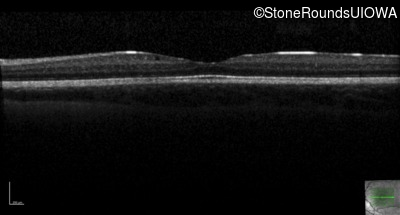
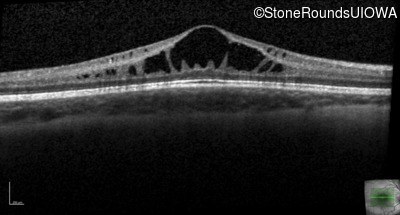
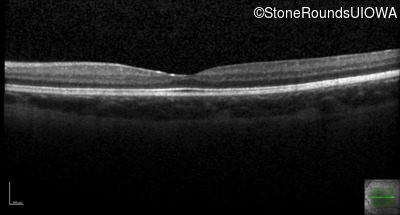
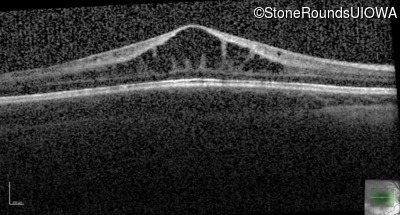
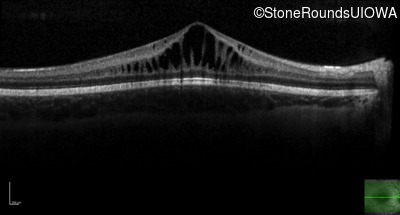
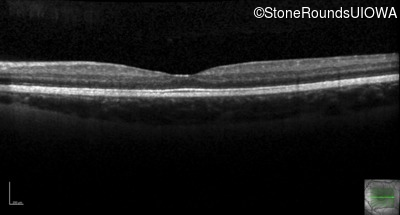
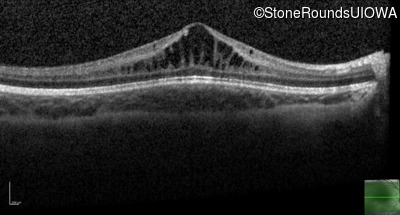
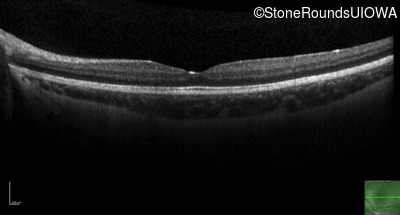
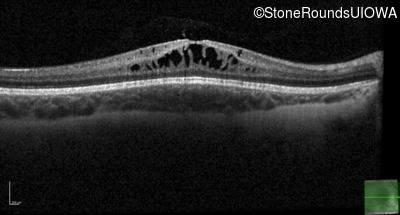
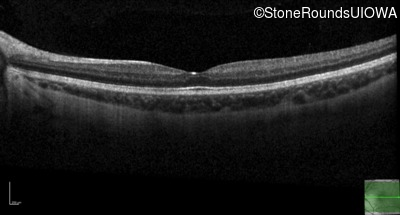
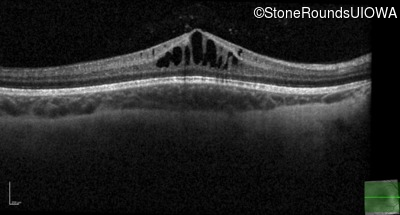

Case
SR316
Student Mode
XL Retinoschisis (IIIB1)
Male
Male
Hidden
SR316
Student Mode
XL Retinoschisis (IIIB1)
Male
Male
History
This 6 year old boy first experienced difficulty reading and seeing the blackboard at age 5.
| Age at visit: 6 years |
| Age at visit: 11 years |
| OD | OS | ||
|---|---|---|---|
| OD | OS | ||
|---|---|---|---|
| Age at visit: 14 years |
| OD | OS | ||
|---|---|---|---|
| OD | OS | ||
|---|---|---|---|
| OD | OS | ||
|---|---|---|---|
| Age at visit: 14 years (Visit 2) |
| OD | OS | ||
|---|---|---|---|
Diagnosis & molecular findings
| Disease | Gene | Allele 1 variant(s) | Allele 2 variant(s) | Inheritance mode |
|---|---|---|---|---|
| XL Retinoschisis | RS1 | Pro192His CCC>CAC | XL |